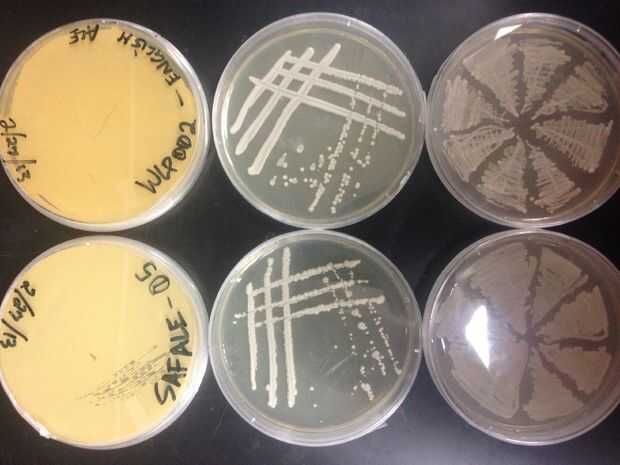
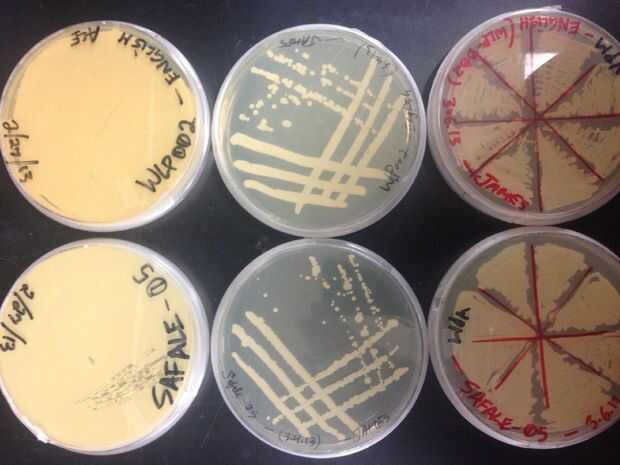

En este tutorial usted aprenderá cómo hacer placas personalizadas con quilling técnicas en muy pocos pasos. Vamos a empezar.Bueno espero que haya disfrutado de este arte y si es así, no olvide compartir, comentar, gusta y suscribirse.Sigueme en Faceb
Sedums son plantas sorprendentes. Son muy apenas y disfrute de negligencia, las grandes plantas para las personas con vidas ocupadas.En este instructable, te voy a mostrar cómo combinar su propio medio de cultivo con materiales desviados la corrient
Cómo hacer placas personalizadas con Quilling las tiras de papel | DIY Quilled carta en papel | Decoración para el hogarEn este tutorial usted aprenderá cómo hacer placas personalizadas con quilling técnicas en muy pocos pasos. Vamos a empezar.En est
En este tutorial usted aprenderá cómo hacer placas personalizadas con quilling técnicas en muy pocos pasos. Vamos a empezar.Bueno espero que haya disfrutado de este arte y si es así, no olvide compartir, comentar, gusta y suscribirse.Sigueme en Faceb
peso olímpico es bastante caro, y pueden ser molesto comprar más cuando llegue el momento. Si, como muchos entusiastas de la halterofilia, comenzó con un conjunto de placas estándar (1"), o algunos han acumulado a lo largo de la manera, puede darles
https://www.youtube.com/watch?v=xot0kDr5NkkPaso 1: Pintura fichas Hacer placas miniatura pintura fichas o dejarlas como están.
Pantalones con bolsillos en la espalda pero no me gusta tener cosas en estoy, sobre todo cuando estoy manejando o haciendo cosas de actividad (como la fijación de un neumático plano..) :-(Al mismo tiempo suele llevar un pequeño cuaderno, el tipo de p
¿quieres hacer pulseras para niñas? Si es así, nunca puede faltar tutorial de Pandahall de hoy sobre cómo hacer pulsera cabujón de cristal con perlas para niñas!Paso 1: Materiales necesarios para la pulsera cabujón de cristal:Cadena de giro de hierro
cómo hacer una cerbatana y dardos con artículos para el hogarEsta es una muy simple y potente poco cerbatana que puede diseñar y hacer usando elementos que se encuentran en el país. Se revienta globos y perforar una manzana desde una corta distancia
si tu japones, Coreano o chino y tener hijos que no sabe cómo usar los palillos, podría hacer un barato fácil de usar palillos para que los niños que no saben cómo utilizar los palillos. Incluso todo el mundo podría usar mi manera barato fácil de usa
¿Todos sabemos lo que sucede cuando se mezclan con vinagre y bicarbonato de sodio, derecho? Si no sabes, pruebalo y luego regresar a este instructable porque voy a mostrar cómo se puede lograr una simple broma con ese efecto muy químico.Salsa de toma
¡Hola a todos!Recientemente, después de semanas tras semanas de investigación (como 5 semanas quizá) ive por fin resuelto un gran problema personal.Vendo pigmentos termocrómicos (y otros pigmentos de efectos especiales, materiales, ect), y con tanto,
Este Instructable cubre un conjunto estándar de cornhole juntas de construcción. Si usted está interesado en la construcción de un sistema de jerarquización, mi Instructable muestra cómo aquí:Si desea obtener verdadero lujo y hacer un balanceo set, a
usuario de la computadora promedio por lo menos ha oído hablar de «Linux». Ahora hay probablemente unos cuatro razones están leyendo esto ahora. Uno, quieres arrancar Windows en medios flash. Dos, quiero poner Mac OS en medios flash. Tres, quiero pon